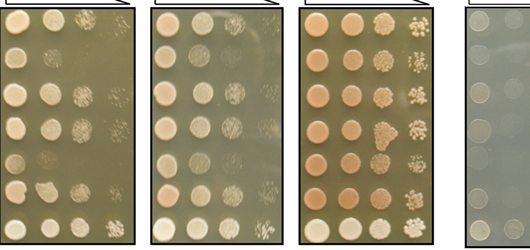

About the Program
- More than 40 faculty members with varied research interests contribute to the activities of the program.
- The program is “home” to first year students; at the end of the first year, students choose a Ph.D. program (usually Biochemistry) and permanent advisor.
Advisors and Ph.D. Programs
- In the first year of study, students complete 3 or 4 research rotations before choosing a permanent advisor.
- Students matriculate into the Ph.D. program in Biochemistry or may choose another program at the end of the first year of study.
Financial Aid
Important Dates
- Completed applications must be received by December 15th for consideration for Fall semester admission (new students are only admitted for Fall semester).
A Safe, Welcoming and Supportive Environment for Graduate Study
We encourage students to investigate the academic and social climate in which they will be working. We recognize that recent allegations and an independent investigation may have raised questions about choosing the University of Rochester for your graduate studies. The University is deeply committed to providing a safe, inclusive and supportive learning environment for graduate students. We are taking steps to further strengthen that commitment.
- The CARE network—our nationally recognized program for expressing concern about any person, incident or issue in the University community and getting support to address it—serves all graduate and post-baccalaureate students as well as University undergraduates.
- Our Ombudsperson Program for graduate students and postdoctoral appointees adds a layer of confidential and independent support for discussing any concern and also for reporting inappropriate behavior.
- The Office of University Engagement and Enrichment promotes a community where everyone feels seen, heard, and empowered, and is tasked with ensuring that policies and practices to support learners are clear, consistent, and communicated effectively across all medical center education programs.
Our goal is to provide a first-class research and training environment in which faculty, learners and staff are united by mutual respect and the love of science. You’ll see this in Dean Mark Taubman’s response to the independent investigator’s report and the welcome message from Richard Feldman, interim president designate for the University. Find more resources and information on this website or talk to your program representative if you have questions.
PhD Applicants
- Full tuition scholarship, including all academic fees. Tuition and Fee Schedule
- A competitive stipend for 2026-2027 of $35,100 per year for 12-month programs or $29,250 per year for 10-month programs.
- Single coverage AETNA student health insurance policy.
- Refund Schedule
Health Insurance
The University Health Service(UHS) provides a full range of confidential, high-quality primary health care services for full-time students and other members of the University community.
Full-time students participate in the Student Health Program, which covers primary care visits to UHS, time-limited therapy at the University Counseling Center (UCC), and health promotion services.
UHS offers health insurance for individual full-time University of Rochester students and their spouses/domestic partners through AETNA. Full-time students are required to participate in this plan unless they complete the Health Insurance Selection Process indicating they are waiving the insurance plan because they have other insurance. Insurance for spouses/partners and families is available for a fee payable by the student.
Childcare Program
The University of Rochester is implementing a pilot childcare grant program for full-time PhD students on university appointments who are parents of children newborn through age 6 (“student-parents”). The objective of this program is to provide some financial assistance to Rochester PhD students with childcare expenses. Additional details can be found at https://www.rochester.edu/graduate-education/phd-students/childcare-grant/.
Related Departments